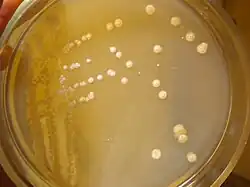

Streptomyces gardneri
| Streptomyces gardneri | |
|---|---|
![]() | |
| Streptomyces gardneri strain ChNPU F3 | |
| Scientific classification | |
| Domain: | Bacteria |
| Kingdom: | Bacillati |
| Phylum: | Actinomycetota |
| Class: | Actinomycetia |
| Order: | Streptomycetales |
| Family: | Streptomycetaceae |
| Genus: | Streptomyces |
| Species: | S. gardneri |
| Binomial name | |
| Streptomyces gardneri (Waksman 1942) Waksman 1961 (Approved Lists 1980)[1] | |
| Type strain | |
| ATCC 23911, ATCC 9604, BCRC 12346, BCRC 13687, BCRC 13731, CBS 832.68, CCRC 12346, CCRC 13687, CCRC 13731, CGMCC 4.1210, CGMCC 4.1956, DSM 40064, DSM 43020, ETH 28347, IFO 12865, IFO 13974, IFO 3385, IMET 7182, IMRU 3834, ISP 5064, JCM 3004, JCM 4375, KCC A-0004, KCC S-0375, NBRC 12865, NBRC 13974, NBRC 3385, NCTC 6531, NRRL B-5615, NRRL-ISP 5064, RIA 1117, RIA 634, VKM Ac-1829 | |
| Synonyms[2] | |
| |
Streptomyces gardneri is a bacterium species from the genus of Streptomyces.[1][3] Streptomyces gardneri produces thiopeptide A, proactinomycin A, proactinomycin B, proactinomycin C.[3][4]
See also
References
- 1 2 LPSN bacterio.net
- ↑ Stephen W., Queener (1986). Antibiotic- Producing Stetomyces. Oxford: Elsevier Science. ISBN 0-323-16293-2.
- 1 2 Deutsche Sammlung von Mikroorganismen und Zellkulturen
- ↑ Stewart, C.S.; Hobson, P.N. (1997). The Rumen Microbial Ecosystem. Dordrecht: Springer Netherlands. ISBN 94-009-1453-9.
Further reading
- Debono, Manuel; Molloy, R. Michael; Occolowitz, John L.; Paschal, Jonathan W.; Hunt, Ann H.; Michel, Karl H.; Martin, James W. (September 1992). "The structures of A10255 B, -G and -J: new thiopeptide antibiotics produced by Streptomyces gardneri". The Journal of Organic Chemistry. 57 (19): 5200–5208. doi:10.1021/jo00045a037.
- Boeck, LD; Berry, DM; Mertz, FP; Wetzel, RW (August 1992). "A10255, a complex of novel growth-promoting thiopeptide antibiotics produced by a strain of Streptomyces gardneri. Taxonomy and fermentation studies". The Journal of Antibiotics. 45 (8): 1222–30. doi:10.7164/antibiotics.45.1222. PMID 1399842.
- Bergey's Manual of Systematic Bacteriology (2nd ed.). New York: Springer Science + Business Media. 2012. ISBN 978-0-387-68233-4.
- Buckingham, J., ed. (1994). Dictionary of natural products. Ya Cai (principal contributor) (1 ed.). London [u.a.]: Chapman & Hall. ISBN 0-412-46620-1.
- Bristol, James A., ed. (1990). Annual Reports in Medicinal Chemistry, 25. John M. McCall (section editor). Burlington: Elsevier. ISBN 0-08-058369-5.
External links